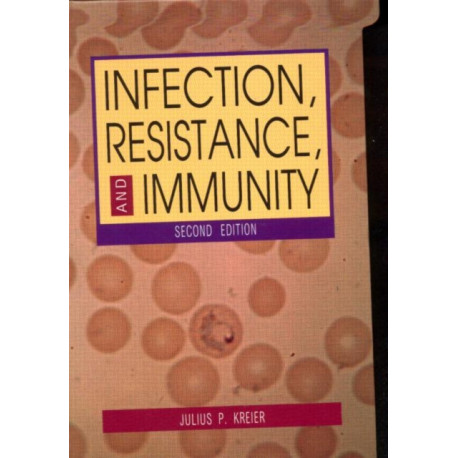

Kurv
Vare
varer
(tom)
Ingen varer
Fastlægges senere
Forsendelse
0,- kr
I alt
Infection, Resistance, and Immunity, Second Edition
(Bog, Hardback, Engelsk)
Forlag:
Gordon and Breach
- Type: Bog
- Format: Hardback
-
Sprog:
Engelsk

- ISBN-13: 9789057025952
- Se flere detaljer ▼
Læsernes anmeldelser (0)
Alle detaljer
| Forlag | Gordon and Breach |
| Forfatter | Julius Kreier |
| Type | Bog |
| Format | Hardback |
| Sprog | Engelsk |
| Udgivelsesdato | 21-11-2001 |
| Første udgivelsesår | 2001 |
| Originalsprog | Netherlands |
| Sideantal | 514 |
| Indbinding | Hardback |
| Forlag | Gordon and Breach |
| Sideoplysninger | 514 pages |
| Mål | 256 x 181 x 34 |
| ISBN-13 / EAN-13 | 9789057025952 |

